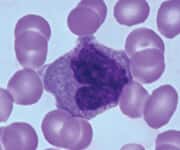
Immune system cells taken from thymus gland

Life Extension Magazine.
Research has increasingly been finding ways to reverse aging in laboratory animals, and much of this research could also benefit humans. Some age-reversal therapies are currently being used by self-experimenters.
During the last year or two, scientists have continued to work and think about solving problems to relieve the suffering caused by aging.
This article describes presentations by scientists at 2021 aging conferences which I found most inspiring.
Therapy for Cancer and Senescent Cells
Peter de Keizer, PhD (Associate Professor, UMC Utrecht University, Utrecht, Netherlands) is developing therapeutic interventions against cancer and senescent cells. Senescent cells are cells that cease to perform normal functions, but which produce chemicals (cytokines) that induce chronic inflammation. The increase in senescent cells with age is believed to contribute to most age-related diseases.1 Therapies that eliminate senescent cells have been shown to extend healthy lifespan in mice.2,3 Senescent cells can be cleared by immune system cells, but with age, immune cells themselves become senescent, creating a vicious cycle of increasing numbers of senescent cells as age progresses.4
Dr. de Keizer is concerned that there are many different types of senescent cells, and that therapies to eliminate senescent cells only eliminate a few subtypes, but not others.5 In addition, he is concerned that chemotherapy and radiation therapy not only kill cancer cells, but cause many cells to become senescent.6-8 The proinflammatory factors secreted by those senescent cells enhance the ability of surviving cancer cells to spread into other tissues (metastasis).9 Dr de Keizer believes that therapies targeting senescent cells should be used along with therapies against cancer.10
Dr. de Keizer has created a cell-penetrating peptide that potently kills senescent cells. Unlike other senescent cell therapies, his peptide is more selective for senescent cells.11,12
Dr. de Keizer has co-founded the company Cleara Biotech (www.clearabiotech.com) dedicated to finding even more effective cell-penetrating peptides to kill senescent cells in the context of cancer therapy. Dr. de Keizer has been raising funds from venture capitalists and has hopes to begin human clinical trials in the near future.
SIRT6 Against Cancer and Aging
Vera Gorbunova, PhD (Co-director Rochester Aging Research Center, University of Rochester, Rochester, New York) is an expert on DNA damage, DNA stability, the effects of SIRT6, and the role these factors play in aging and cancer.
Cancer is a disease of altered DNA, which causes cancer cells to cease their normal functions and instead to simply reproduce and spread. Aging too is a disease of altered DNA, causing cells to lose their ability to reproduce and perform their normal functions in organs and tissues.
DNA controls all cell functions, but with age DNA not only becomes less stable,13 but becomes more likely to become damaged.14 Both the lack of stability15 and the increasing DNA damage contribute to the chronic inflammation which causes most age-related diseases, including cardiovascular disease,16 Alzheimer’s Disease,17 and cancer.18 DNA damage is a major cause of cellular senescence.1
Humans have seven sirtuin enzymes (SIRT1 to SIRT7), which perform a wide variety of functions important for health and longevity.19 Dr. Gorbunova is a world expert on SIRT6, which her team has shown maintains DNA stability,15 and enhances repair of DNA damage.20 Comparing different rodent species of varying lifespans (from 3 to 32 years) her team has shown that the efficiency of the SIRT6 enzyme for DNA repair corresponds to the maximum lifespan of a rodent species.20 Other researchers have shown that SIRT1 has many health benefits and that SIRT6 has been shown to extend lifespan of mice.21
For many years Life Extension® funded Dr. Gorbunova’s SIRT6 research. Noting that resveratrol and similar chemicals enhance the enzyme activity of SIRT1, Dr. Gorbunova sought chemicals which could enhance SIRT6 activity.22 Many SIRT6 activators have been found,23 including the Asian seaweed polysaccharide fucoidan.
The Role of Macrophages in Aging
Eric Verdin, MD (CEO, Buck Institute for Research on Aging, Novato, California) has been investigating the role of macrophages in aging and aging-related diseases.
Macrophages are a type of white blood cell of the immune system that engulfs and digests microbes, cellular debris, and other contaminants. The word macrophage was derived from Greek (macro=big, phage=eater) by the scientist who discovered these cells. Macrophages play an important role in the progression of inflammation-related diseases, including atherosclerosis, diabetes, and cancer.24 Macrophages can be either inflammatory ( M1 macrophages, which produce inflammatory responses) or anti-inflammatory (M2 macrophages, which are attracted to sites of inflammation and produce anti-inflammatory responses).25 With aging, macrophages become increasingly of the M1 type, contributing to chronic inflammation.26
Aging is also characterized by an increasing number of senescent cells.27 Macrophages are attracted to senescent cells to engulf and remove them.28 But collections of macrophages and senescent cells become increasingly pro-inflammatory, causing nearby cells to become senescent, possibly also including the macrophages themselves.28 The pro-inflammatory macrophages increasingly express the CD38 enzyme which degrades the important enzymatic co-factor NAD+.29 The loss of NAD+ with age results in reduced function of sirtuins and other enzymes required for DNA repair, and reduced capacity of the immune system to function optimally.30
Dr. Verdin presented evidence for the hypothesis that senescent macrophages are a substantial source of NAD+ loss and of senescent cells in aging.31,32
Immune System Rejuvenation
Gregory Fahy, PhD (Chief Scientific Officer and Co-founder, Intervene Immune, Torrance, California) described the TRIIM (Thymus Regeneration, Immunorestoring, and Insulin Mitigation) clinical trial that he designed and led, as well as the follow-up extended (TRIIM-X) trial which he is leading, and which is still seeking participants. TRIIM was a pilot study of nine male adults, but TRIIM-X has been seeking 85 adults of diverse gender and ethnicity for a study to be completed in November 2022.
The TRIIM trial was designed to regenerate the thymus gland using growth hormone, while attempting to prevent the growth hormone from causing diabetes. Metformin and dehydroepiandrosterone (DHEA) were the anti-diabetic agents.33
Dr. Fahy had been inspired to attempt the TRIIM trial by his knowledge that growth hormone has been shown to reconstitute the thymus in rats,34 dogs,35 and HIV-infected patients.36
With age, immune system function declines, leaving elderly persons vulnerable to infection. Persons 65 years or older account for 90% of influenza-related deaths in the United States.37 Immune system cells produced by the thymus gland (T-cells) decline in function with age,38 due to the fact that the thymus gland shrinks and becomes clogged with fat early in life.39 Fresh (“naive”) T-cells decline by about two orders of magnitude (hundreds of times) between the ages of 20 and 70.40
Many animal experiments have shown that reduced growth hormone early in life leads to healthy longevity.41 By contrast, the TRIIM trial showed that growth hormone given late in life reversed the biological age of nine men an average of 1.5 years,33 as indicated by DNA methylation “clocks”.42-45 Not only was T-cell function improved, but there were fewer immune cells expressing the NAD+ depleting enzyme CD38. NAD+ decline with age underlies many age-related diseases, such that restoration of NAD+ could be rejuvenating.46
Neural Networks to Predict Biological Age
Alex Zhavoronkov, PhD (CEO, Insilico Medicine, Hong Kong Science Park, Hong Kong) is a scientist and entrepreneur who is employing the deep neural network form of artificial intelligence to understand human aging. Neural networks are computer programs that simulate the way neurons interact to cause learning in the human brain. A neural network is deep when it contains many layers of simulated neurons. Unlike conventional computer programs which are given explicit instructions by a computer programmer, neural networks are simply “trained” by data to produce a result without the programmer knowing the details by which the simulated neurons produced that result.
Dr. Zhavoronkov has been inspired in his neural network efforts by the use of DNA methylation clocks to predict human age.44 Dr. Zhavoronkov trained deep neural networks on 60,000 human blood samples and thereby identified five blood components that could be used to predict human age.47 Predicting biological age can be valuable in human longevity studies because it allows a way of measuring whether a relatively shortterm therapeutic intervention successfully slows or reverses aging, rather than having to wait decades for a human lifespan to play out.
Using deep neural networks to analyze the blood samples of people of different nationalities, Dr. Zhavoronkov’s team determined that South Koreans tend to have a predicted age younger than their chronological age, whereas for Eastern Europeans the predicted age is older.48
Among his efforts as an entrepreneur, in addition to founding Insilico Medicine (insilico.com, which searches for longevity drugs using artificial intelligence), Dr. Zhavoronkov has founded Deep Longevity (deeplongevity.com, which specializes in aging clocks), and Longevity Medicine (longevity-medicine.org, which offers a Longevity Medicine Course (longevity.degree) for medical professionals.
Administering $350 million for Rejuvenation Research
Patrick Burgermeister (Partner, Kizoo Technology Ventures, Germany) spoke about the role of Kizoo Technology Ventures (www.kizoo.com) in providing seed funding, mentoring, and follow-on financing for biotechnology companies focused on rejuvenation.
Kizoo is part of the Forever Healthy Foundation (https://forever-healthy.org/) founded by internet entrepreneur Michael Greve. Greve has also funded the annual Undoing Aging conferences in Berlin, Germany (collaborating with the rejuvenation-focused SENS Foundation). In May 2021 Greve committed an additional 300 million EUROs (about $350 million) for support of rejuvenation biotechnology startups. Greve believes that abolishing cancer, heart attacks, and dementia is just a matter of time, money, and research.
Mr. Burgermeister said that Kizoo funding contrasts with that of typical investors looking for low-risk companies that will soon be profitable. He said that Kizoo prefers companies in the earliest stages of development (sometimes not even yet founded). Kizoo prefers to lead the way, in contrast to “lightweight investors,” who look for companies which already have funding from many other investors.
Kizoo prefers companies in which the founders have a strong financial interest. Some of the companies that Kizoo has funded include Underdog Pharmaceutical (clearing non-degradable cholesterol from arteries), Revel Pharmaceutical (therapeutic enzymes to degrade age-associated molecular damage), Cellvie (mitochondrial augmentation and replacement), and Turn Biotechnologies (epigenetically reprogramming cells to be younger), among other companies. Mr. Burgermeister serves as a director for some of the Kizoo-funded companies.
Concluding Remarks
It is encouraging to see not only the development of therapies to slow aging, but to potentially reverse aging. The advent of this potential has gratifyingly brought increasing amounts of money into aging research, along with entrepreneurial activity associated with therapies.
If you have any questions on the scientific content of this article, please call a Life Extension Wellness Specialist at 1-866-864-3027.
References
- Amaya-Montoya M, Perez-Londono A, Guatibonza-Garcia V, et al. Cellular Senescence as a Therapeutic Target for Age-Related Diseases: A Review. Adv Ther. 2020 Apr;37(4):1407-24.
- Suda M, Shimizu I, Katsuumi G, et al. Senolytic vaccination improves normal and pathological age-related phenotypes and increases lifespan in progeroid mice. Nature Aging. 2021 2021/12/01;1(12):1117-26.
- Xu M, Pirtskhalava T, Farr JN, et al. Senolytics improve physical function and increase lifespan in old age. Nat Med. 2018 Aug;24(8):1246-56.
- Martinez-Zamudio RI, Dewald HK, Vasilopoulos T, et al. Senescence-associated beta-galactosidase reveals the abundance of senescent CD8+ T cells in aging humans. Aging Cell. 2021 May;20(5):e13344.
- Lehmann J, Baar MP, de Keizer PLJ. Senescent Cells Drive Frailty through Systemic Signals. Trends Mol Med. 2018 Nov;24(11):917-8.
- De Blander H, Morel AP, Senaratne AP, et al. Cellular Plasticity: A Route to Senescence Exit and Tumorigenesis. Cancers (Basel). 2021 Sep 11;13(18).
- Baskar R, Lee KA, Yeo R, et al. Cancer and radiation therapy: current advances and future directions. Int J Med Sci. 2012;9(3):193-9.
- Liu B, Ezeogu L, Zellmer L, et al. Protecting the normal in order to better kill the cancer. Cancer Med. 2015 Sep;4(9):1394-403.
- Simay Demir YD, Ozdemir A, Sucularli C, et al. The implication of ROCK 2 as a potential senotherapeutic target via the suppression of the harmful effects of the SASP: Do senescent cancer cells really engulf the other cells? Cell Signal. 2021 Aug;84:110007.
- Liu XL, Ding J, Meng LH. Oncogene-induced senescence: a double edged sword in cancer. Acta Pharmacol Sin. 2018 Oct;39(10): 1553-8.
- Baar MP, Brandt RMC, Putavet DA, et al. Targeted Apoptosis of Senescent Cells Restores Tissue Homeostasis in Response to Chemotoxicity and Aging. Cell. 2017 Mar 23;169(1):132-47 e16.
- van Willigenburg H, de Keizer PLJ, de Bruin RWF. Cellular senescence as a therapeutic target to improve renal transplantation outcome. Pharmacol Res. 2018 Apr;130:322-30.
- Gorbunova V, Seluanov A, Mita P, et al. The role of retrotransposable elements in ageing and age-associated diseases. Nature. 2021 Aug;596(7870):43-53.
- Schumacher B, Pothof J, Vijg J, et al. The central role of DNA damage in the ageing process. Nature. 2021 Apr;592(7856):695-703.
- Simon M, Van Meter M, Ablaeva J, et al. LINE1 Derepression in Aged Wild-Type and SIRT6-Deficient Mice Drives Inflammation. Cell Metab . 2019 Apr 2;29(4):871-85 e5.
- Wu X, Sun M, Yang Z, et al. The Roles of CCR9/CCL25 in Inflammation and Inflammation-Associated Diseases. Front Cell Dev Biol. 2021;9:686548.
- Guerrero A, De Strooper B, Arancibia-Carcamo IL. Cellular senescence at the crossroads of inflammation and Alzheimer’s disease. Trends Neurosci. 2021 Sep;44(9):714-27.
- Serrano-Lopez J, Martin-Antonio B. Inflammaging, an Imbalanced Immune Response That Needs to Be Restored for Cancer Prevention and Treatment in the Elderly. Cells. 2021 Sep 28;10(10).
- Grabowska W, Sikora E, Bielak-Zmijewska A. Sirtuins, a promising target in slowing down the ageing process. Biogerontology. 2017 Aug;18(4):447-76.
- Tian X, Firsanov D, Zhang Z, et al. SIRT6 Is Responsible for More Efficient DNA Double-Strand Break Repair in Long-Lived Species. Cell. 2019 Apr 18;177(3):622-38 e22.
- Roichman A, Elhanati S, Aon MA, et al. Restoration of energy homeostasis by SIRT6 extends healthy lifespan. Nat Commun. 2021 May 28;12(1):3208.
- Van Meter M, Gorbunova V, Seluanov A. SIRT6: a promising target for cancer prevention and therapy. Adv Exp Med Biol. 2014;818:181-96.
- Akter R, Afrose A, Rahman MR, et al. A Comprehensive Analysis into the Therapeutic Application of Natural Products as SIRT6 Modulators in Alzheimer’s Disease, Aging, Cancer, Inflammation, and Diabetes. Int J Mol Sci. 2021 Apr 17;22(8).
- Shapouri-Moghaddam A, Mohammadian S, Vazini H, et al. Macrophage plasticity, polarization, and function in health and disease. J Cell Physiol. 2018 Sep;233(9):6425-40.
- Yunna C, Mengru H, Lei W, et al. Macrophage M1/M2 polarization. Eur J Pharmacol. 2020 Jun 15;877:173090.
- Yarbro JR, Emmons RS, Pence BD. Macrophage Immunometabolism and Inflammaging: Roles of Mitochondrial Dysfunction, Cellular Senescence, CD38, and NAD. Immunometabolism. 2020;2(3):e200026.
- Childs BG, Gluscevic M, Baker DJ, et al. Senescent cells: an emerging target for diseases of ageing. Nat Rev Drug Discov. 2017 Oct;16(10):718-35.
- Campbell RA, Docherty MH, Ferenbach DA, et al. The Role of Ageing and Parenchymal Senescence on Macrophage Function and Fibrosis. Front Immunol. 2021;12:700790.
- Covarrubias AJ, Kale A, Perrone R, et al. Senescent cells promote tissue NAD(+) decline during ageing via the activation of CD38(+) macrophages. Nat Metab. 2020 Nov;2(11):1265-83.
- Hogan KA, Chini CCS, Chini EN. The Multi-faceted Ecto-enzyme CD38: Roles in Immunomodulation, Cancer, Aging, and Metabolic Diseases. Front Immunol. 2019;10:1187.
- Behmoaras J, Gil J. Similarities and interplay between senescent cells and macrophages. J Cell Biol. 2021 Feb 1;220(2).
- Sharma R. Perspectives on the dynamic implications of cellular senescence and immunosenescence on macrophage aging biology. Biogerontology. 2021 Dec;22(6):571-87.
- Fahy GM, Brooke RT, Watson JP, et al. Reversal of epigenetic aging and immunosenescent trends in humans. Aging Cell. 2019 Dec;18(6):e13028.
- French RA, Broussard SR, Meier WA, et al. Age-associated loss of bone marrow hematopoietic cells is reversed by GH and accompanies thymic reconstitution. Endocrinology. 2002 Feb;143(2):690-9.
- Goff BL, Roth JA, Arp LH, et al. Growth hormone treatment stimulates thymulin production in aged dogs. Clin Exp Immunol. 1987 Jun;68(3):580-7.
- Napolitano LA, Schmidt D, Gotway MB, et al. Growth hormone enhances thymic function in HIV-1-infected adults. J Clin Invest. 2008 Mar;118(3):1085-98.
- Mannick JB, Del Giudice G, Lattanzi M, et al. mTOR inhibition improves immune function in the elderly. Sci Transl Med. 2014 Dec 24;6(268):268ra179.
- Naylor K, Li G, Vallejo AN, et al. The influence of age on T cell generation and TCR diversity. J Immunol. 2005 Jun 1;174(11):7446-52.
- Abbott A. First hint that body’s ‘biological age’ can be reversed. Nature. 2019 Sep;573(7773):173.
- Fulop T, Larbi A, Pawelec G, et al. Immunology of Aging: the Birth of Inflammaging. Clin Rev Allergy Immunol. 2021 Sep 18:1-14.
- Sadagurski M, Landeryou T, Cady G, et al. Growth hormone modulates hypothalamic inflammation in long-lived pituitary dwarf mice. Aging Cell. 2015 Dec;14(6):1045-54.
- Lu AT, Quach A, Wilson JG, et al. DNA methylation GrimAge strongly predicts lifespan and healthspan. Aging (Albany NY). 2019 Jan 21;11(2):303-27.
- Hannum G, Guinney J, Zhao L, et al. Genome-wide methylation profiles reveal quantitative views of human aging rates. Mol Cell. 2013 Jan 24;49(2):359-67.
- Horvath S. DNA methylation age of human tissues and cell types. Genome Biol. 2013;14(10):R115.
- Levine ME, Lu AT, Quach A, et al. An epigenetic biomarker of aging for lifespan and healthspan. Aging (Albany NY). 2018 Apr 18;10(4):573-91.
- Fang EF, Lautrup S, Hou Y, et al. NAD(+) in Aging: Molecular Mechanisms and Translational Implications. Trends Mol Med. 2017 Oct;23(10):899-916.
- Putin E, Mamoshina P, Aliper A, et al. Deep biomarkers of human aging: Application of deep neural networks to biomarker development. Aging (Albany NY). 2016 May;8(5):1021-33.
- Mamoshina P, Kochetov K, Putin E, et al. Population Specific Biomarkers of Human Aging: A Big Data Study Using South Korean, Canadian, and Eastern European Patient Populations. J Gerontol A Biol Sci Med Sci. 2018 Oct 8;73(11):1482-90.